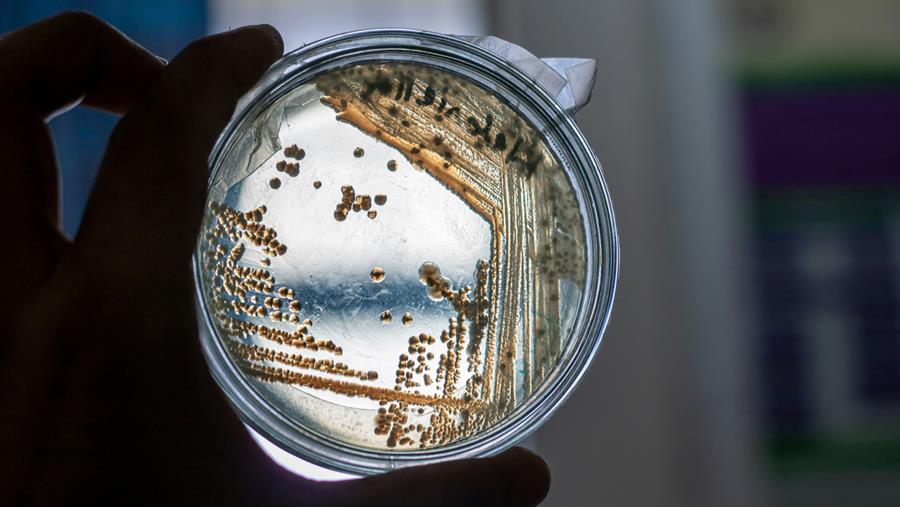
Antibiorésistance: une défense bactérienne à trois niveaux

- 22 août 2025
- En La rédaction (avec Belga)
- | Source: Artsenkrant
Antibiorésistance: une défense bactérienne à trois niveaux
Des chercheurs de l'UCLouvain ont découvert que les trois couches distinctes qui composent l'enveloppe des bactéries agissent de concert pour assurer leur protection.
Lisez cet article gratuitement ?
Inscrivez-vous et devenez abonné en ligne gratuitement
Vous êtes déjà abonné?
Inscrivez-vous pour profiter d'un accès illimité à notre site Web.
En vous inscrivant, vous recevrez le newsletter. Vous pouvez suspendre le newsletter à tout moment et sans autres formalités. Nous garantissons que votre adresse e-mail et autres données personnelles ne seront jamais communiquées à des tiers et seront uniquement utilisées pour l'envoi du newsletter.
En vous inscrivant, vous acceptez Les conditions de respect de la vie privée.